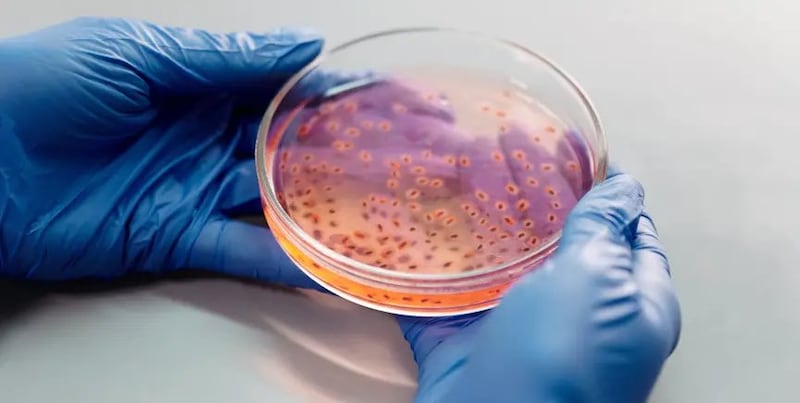
El gen móvil npmA2

La Organización Mundial de la Salud (OMS) confirmó esta semana un nuevo caso del virus de Marburgo en Etiopía, un brote que mantiene en alerta a las autoridades sanitarias por su alta tasa de letalidad y su rápida propagación. El organismo llamó a reforzar la vigilancia epidemiológica luego de que 12 personas dieran positivo y ocho fallecieran en ese país.
Un virus altamente letal
De acuerdo con la OMS, el virus de Marburgo —junto con el virus Ravn— pertenece a la especie Orthomarburgvirus marburgense y provoca una enfermedad clínicamente similar al Ébola. Aunque es poco frecuente, puede causar brotes con tasas de mortalidad de hasta 88%, cifra que disminuye cuando hay atención médica oportuna.
El virus fue identificado por primera vez en 1967 en Alemania y Serbia, en trabajadores de laboratorio que habían tenido contacto con monos verdes africanos provenientes de Uganda. Desde entonces se han registrado brotes en países como Angola, Congo, Ghana, Guinea, Kenia, Ruanda, Sudáfrica, Tanzania y Uganda.
¿Cómo se transmite?
La OMS señala que la infección inicial en humanos ocurre por exposición prolongada a cuevas o minas habitadas por murciélagos frugívoros Rousettus, considerados hospedadores naturales del virus.
Una vez dentro de la población, la enfermedad se transmite de persona a persona por contacto directo con sangre, fluidos corporales u órganos de personas infectadas, así como por superficies contaminadas.
El personal médico ha resultado contagiado en brotes anteriores por no aplicar correctamente las medidas de control de infecciones. Además, las ceremonias funerarias representan un riesgo alto cuando hay contacto directo con el cuerpo de un fallecido por la enfermedad.

Síntomas del virus de Marburgo
El periodo de incubación va de 2 a 21 días. La enfermedad inicia de forma abrupta con:
- Fiebre alta
- Dolor de cabeza intenso
- Malestar general
- Dolores musculares
A partir del tercer día pueden presentarse:
- Diarrea acuosa intensa
- Dolor abdominal y cólicos
- Náuseas y vómitos
- Erupciones cutáneas
Entre el quinto y séptimo día, los pacientes pueden desarrollar hemorragias internas y externas, como sangrado nasal, en encías, vómito con sangre y sangre en heces. También pueden presentar irritabilidad, confusión, agresividad y, en casos avanzados, inflamación testicular.
En los casos fatales, la muerte suele ocurrir entre ocho y nueve días después del inicio de síntomas, generalmente por pérdida masiva de sangre y shock.
Tratamiento y atención
Actualmente no existen vacunas ni antivirales aprobados contra el virus de Marburgo. El tratamiento consiste en:
- Rehidratación intensiva
- Manejo de síntomas específicos
- Atención médica temprana
La OMS informó que hay anticuerpos monoclonales, antivirales y vacunas candidatas en evaluación clínica.
El director general de la OMS, Tedros Adhanom, advirtió que el brote sigue activo en Etiopía y llamó a mantener la vigilancia y el rastreo de contactos para evitar una propagación mayor.
